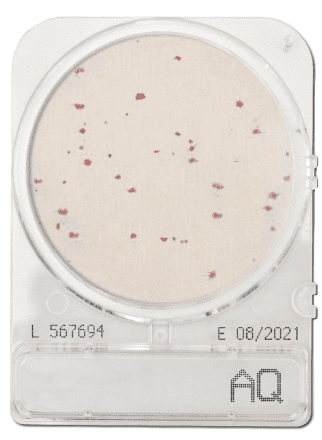

CompactDry AQ for water heterotrophic bacteria.
CompactDry AQ plates contains a chromogenic nutrient poor medium for determining the colony count of heterotrophic organisms in treated drinking water and ultra-pure water.
Colonies are almost all red. Yeast tends to grow as white-pink colonies. Moulds grow as a typical 3-dimensional cotton wool form.